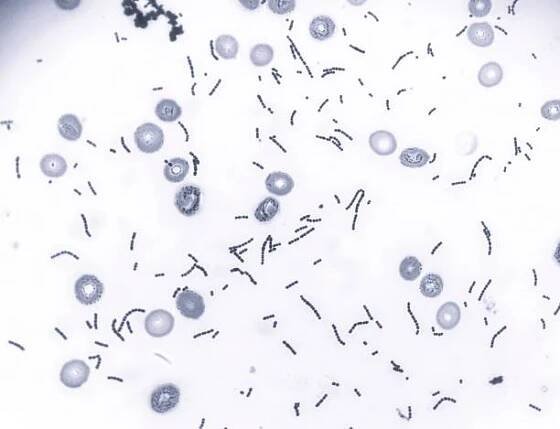

Nabídky ze Zboží.cz
4,8 (59)
Do 3 dnů
od 85 Kč
326 Kč
Altoa-essentials.cz
4,6 (183)
Skladem
od 99 Kč
349 Kč
MJ-KrasaZdravi.cz
4,8 (59)
Do 3 dnů
od 85 Kč
448 Kč
Altoa-essentials.cz
4,8 (59)
Do 3 dnů
od 89 Kč
449 Kč
Hillvitalshop.cz
4,7 (377)
Skladem
od 79 Kč
589 Kč
BENU Lékárna
Skladem
od 79 Kč
359 Kč
BENU Lékárna
4,9 (27)
Skladem
Zdarma
2 739 Kč
Puravia.cz
5,0 (15)
Skladem
od 99 Kč
1 289 Kč
Puravia.cz
4,7 (377)
Skladem
od 99 Kč
599 Kč
MJ-KrasaZdravi.cz
4,7 (377)
Skladem
od 59 Kč
499 Kč
Dr.Max Lékárna
Skladem
od 129 Kč
529 Kč
Koloidní stříbro s.r.o.
Skladem
od 100 Kč
720 Kč
Interkontakt.store
Skladem
od 129 Kč
529 Kč
Koloidní stříbro s.r.o.
4,7 (377)
Skladem
od 79 Kč
650 Kč
internetLÉKÁRNA.cz
4,7 (377)
Do 3 dnů
od 99 Kč
467 Kč
Alza.cz
4,5 (7)
Skladem
od 129 Kč
369 Kč
ViaNubia
4,8 (59)
Skladem
od 129 Kč
339 Kč
ViaNubia
4,7 (3)
Skladem
od 109 Kč
1 199 Kč
FUBO
4,7 (377)
Skladem
od 79 Kč
570 Kč
Onlinelekarna.cz
Druh bakterie rodu Streptococcus, která se vyskytuje v dutině ústní a v horních cestách dýchacích člověka. Podílí se na tvorbě zubního plaku. Některé kmeny mohou být patogenní, pokud proniknou do krevního řečiště. Jiné kmeny, např. Streptococcus salivarius K12, produkují bakteriociny a používají se jako probiotika.
Streptococcus salivarius - Wikipedia
Lozenges containing S. salivarius are marketed to support immunity against more virulent Streptococcus strains. People with this strain of naturally occurring S. salivarius on their tongue have been shown to have fewer Strep throat…
Streptococcus Salivarius - Bylinné a minerální přípravky…
Streptococcus Salivarius - Bylinné a minerální přípravky - Nejvíce nabídek na jednom místě. Užijte si nakupování a 100% bezpečnost pro každou transakci. Kup nyní!
Streptococcus salivarius
Všechny kategorie Sleva Akce Akce Jaro Co mě trápí Bylinky Tradiční čínská medicína Ajurvédská medicína (Ayurveda) Probiotika, prebiotika, vláknina Vitamíny, minerály, enzymy Vitální houby, betaglukany Superpotraviny Gemmoterapie Homeopatie…
odkazuje na služby nejen od Seznam.cz.
© 1996–2025 Seznam.cz, a.s.